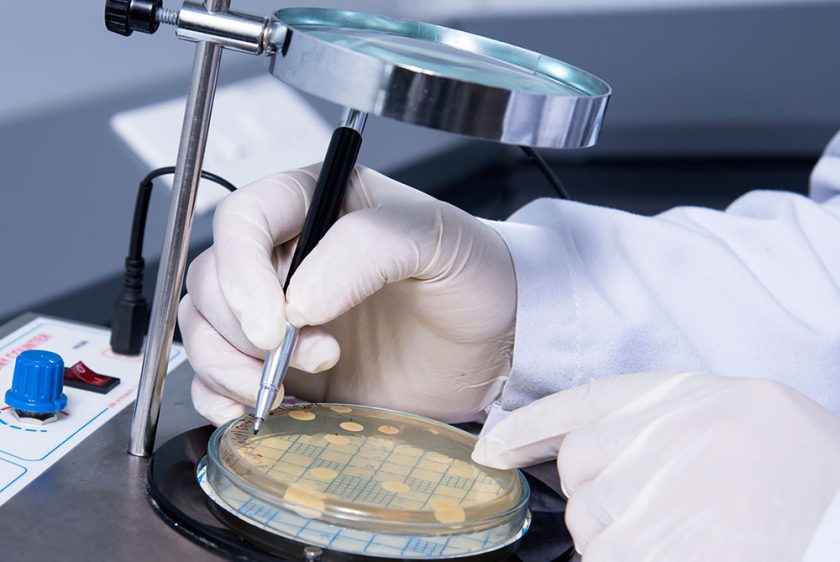

Capabilities
Pontika Aerotech is proud to offer a comprehensive range of capabilities that position us as a leading contract research and manufacturing organization. Whether you need research and development, process engineering, manufacturing excellence, quality management, or packaging innovation, your search ends here. Our capabilities include:

Formulation & Research
Pontika Aerotech excels in formulation and research services, leveraging our scientific expertise and next-gen technologies to develop innovative solutions for clients from various industries. Our dedicated team of researchers and scientists is committed to delivering cutting-edge formulations that meet the highest standards of quality, efficacy, and regulatory compliance, driving the advancement of industry leading products.
Development and Process Engineering
Pontika Aerotech brings expertise in development and process engineering, offering comprehensive solutions to optimize product development and manufacturing processes. Our team of engineers collaborates closely with clients to streamline operations, enhance efficiency, and ensure seamless scalability, resulting in cost-effective and high-quality production, which in turn helps improve the bottom lines of our clients.


Manufacturing
Pontika Aerotech boasts exceptional manufacturing capabilities, providing reliable and efficient production services for Topical Pharmaceuticals, Beauty and Personal care, Ayurveda, Hygiene, Cosmoceuticals, Veterinary, and many other segments. Equipped with state-of-the-art facilities, we deliver cost-effective solutions that meet regulatory standards and ensure the timely delivery of high-quality products in various dosage forms.
Quality Assurance
At Pontika Aerotech, quality is our brand promise. Our dedicated team ensures that every aspect of our research and manufacturing processes adheres to the highest standards of quality control, ensuring product safety, efficacy, and regulatory compliance. With robust quality control measures in place, we guarantee that our clients receive products of the utmost quality and reliability.

Packaging
Pontika Aerotech understands the crucial role packaging plays in product appeal and consumer engagement. With sustainability at the core, along with meticulous attention to detail, we create advanced packaging solutions that enhance product visibility, ensuring a strong market presence for our clients.

 Skin Care
Skin Care
 Veterinary
Veterinary
 Nasal Care
Nasal Care
 Bath and Body
Bath and Body
 Personal Care
Personal Care
 Fragrances
Fragrances
 Pain Management
Pain Management
 Hair Care
Hair Care
 Hygiene Solutions
Hygiene Solutions
 Sexual Wellness
Sexual Wellness
 Mom and Baby
Mom and Baby
 Health
Health
 Oral Care
Oral Care